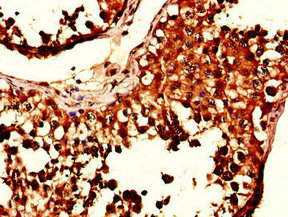

-
中文名稱:SIK1兔多克隆抗體
-
貨號:CSB-PA021321LA01HU
-
規格:¥440
-
圖片:
-
Immunohistochemistry of paraffin-embedded human lung cancer using CSB-PA021321LA01HU at dilution of 1:100
-
Immunohistochemistry of paraffin-embedded human testis tissue using CSB-PA021321LA01HU at dilution of 1:100
-
Immunofluorescent analysis of HepG2 cells using CSB-PA021321LA01HU at dilution of 1:100 and Alexa Fluor 488-congugated AffiniPure Goat Anti-Rabbit IgG(H+L)
-
-
其他:
產品詳情
-
產品名稱:Rabbit anti-Homo sapiens (Human) SIK1 Polyclonal antibody
-
Uniprot No.:
-
基因名:SIK1
-
別名:KID2 antibody; MSK antibody; myocardial SNF1 like kinase antibody; QIK antibody; Qin-induced kinase antibody; Salt inducible kinase 1 antibody; Salt-inducible protein kinase 1 antibody; Serine threonine protein kinase SNF1 like kinase 1 antibody; Serine threonine protein kinase SNF1LK antibody; Serine/threonine-protein kinase SIK1 antibody; Serine/threonine-protein kinase SNF1-like kinase 1 antibody; Serine/threonine-protein kinase SNF1LK antibody; SIK-1 antibody; SIK1 antibody; SIK1_HUMAN antibody; SNF1 like kinase antibody; Snf1lk antibody
-
宿主:Rabbit
-
反應種屬:Human
-
免疫原:Recombinant Human Serine/threonine-protein kinase SIK1 protein (492-750AA)
-
免疫原種屬:Homo sapiens (Human)
-
標記方式:Non-conjugated
本頁面中的產品,SIK1 Antibody (CSB-PA021321LA01HU),的標記方式是Non-conjugated。對于SIK1 Antibody,我們還提供其他標記。見下表:
-
克隆類型:Polyclonal
-
抗體亞型:IgG
-
純化方式:>95%, Protein G purified
-
濃度:It differs from different batches. Please contact us to confirm it.
-
保存緩沖液:Preservative: 0.03% Proclin 300
Constituents: 50% Glycerol, 0.01M PBS, PH 7.4 -
產品提供形式:Liquid
-
應用范圍:ELISA, IHC, IF
-
推薦稀釋比:
Application Recommended Dilution IHC 1:20-1:200 IF 1:50-1:200 -
Protocols:
-
儲存條件:Upon receipt, store at -20°C or -80°C. Avoid repeated freeze.
-
貨期:Basically, we can dispatch the products out in 1-3 working days after receiving your orders. Delivery time maybe differs from different purchasing way or location, please kindly consult your local distributors for specific delivery time.
-
用途:For Research Use Only. Not for use in diagnostic or therapeutic procedures.
引用文獻
- Integrated Bioinformatics and Experimental Validation Reveal Macrophage Polarization-Related Biomarkers for Osteoarthritis Diagnosis Q He, L Liu, X Hu, L Lin, Z Song, Y Xia,Journal of Multidisciplinary Healthcare,2025
相關產品
靶點詳情
-
功能:Serine/threonine-protein kinase involved in various processes such as cell cycle regulation, gluconeogenesis and lipogenesis regulation, muscle growth and differentiation and tumor suppression. Phosphorylates HDAC4, HDAC5, PPME1, SREBF1, CRTC1/TORC1. Inhibits CREB activity by phosphorylating and inhibiting activity of TORCs, the CREB-specific coactivators, like CRTC2/TORC2 and CRTC3/TORC3 in response to cAMP signaling. Acts as a tumor suppressor and plays a key role in p53/TP53-dependent anoikis, a type of apoptosis triggered by cell detachment: required for phosphorylation of p53/TP53 in response to loss of adhesion and is able to suppress metastasis. Part of a sodium-sensing signaling network, probably by mediating phosphorylation of PPME1: following increases in intracellular sodium, SIK1 is activated by CaMK1 and phosphorylates PPME1 subunit of protein phosphatase 2A (PP2A), leading to dephosphorylation of sodium/potassium-transporting ATPase ATP1A1 and subsequent increase activity of ATP1A1. Acts as a regulator of muscle cells by phosphorylating and inhibiting class II histone deacetylases HDAC4 and HDAC5, leading to promote expression of MEF2 target genes in myocytes. Also required during cardiomyogenesis by regulating the exit of cardiomyoblasts from the cell cycle via down-regulation of CDKN1C/p57Kip2. Acts as a regulator of hepatic gluconeogenesis by phosphorylating and repressing the CREB-specific coactivators CRTC1/TORC1 and CRTC2/TORC2, leading to inhibit CREB activity. Also regulates hepatic lipogenesis by phosphorylating and inhibiting SREBF1. In concert with CRTC1/TORC1, regulates the light-induced entrainment of the circadian clock by attenuating PER1 induction; represses CREB-mediated transcription of PER1 by phosphorylating and deactivating CRTC1/TORC1.
-
相關疾病:Epileptic encephalopathy, early infantile, 30 (EIEE30)
-
亞細胞定位:Cytoplasm. Nucleus. Note=Locates to cytoplasm when inactive following cAMP-induced phosphorylation, probably by PKA (PubMed:29211348).
-
蛋白家族:Protein kinase superfamily, CAMK Ser/Thr protein kinase family, AMPK subfamily
-
數據庫鏈接: